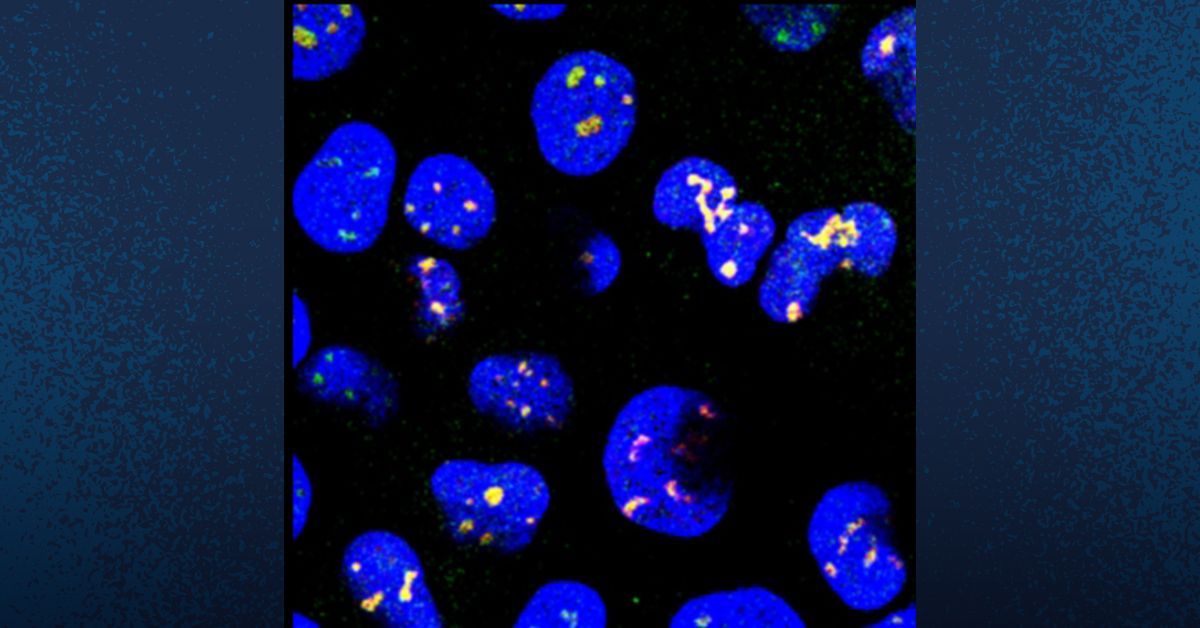
xuashleychen1's tweet card. UC San Diego researchers have helped discover that a drug used to treat pinworms, can be repurposed to rejuvenate cellular structures and potentially treat neurodegenerative diseases like Alzheimer's...

Bokai Zhu lab
@LabZhu
The Zhu lab studies the moon/tide-related 12h ultradian clock; xbp1, proteostasis, epigenetic, metabolism, aging, stress response are the key words. @AgingPitt
Вам может понравиться
It is a great pleasure to share our most recent work on ‘rejuvenating’ nuclear speckles to ameliorate proteinopaties such as Tauopathy and retinitis pigmentosa. It is my first publication that is not related to biological rhythms and I am very excited to nature.com/articles/s4146…
I am so sad to hear the passing of Dr. Bert O’Malley today. He has been a great mentor for me and has always been my inspiration for pursuing science. The world has lost a great scientist and mentor today.

Sadden to hear the passing of Dr. Bert O’Malley, the father of molecular endocrinology, a long-time mentor, and friend.

Pyrvinium as a nuclear speckle rejuvenator independently validated in a new study. SWING domains prime chromatin for nuclear body–mediated gene regulation biorxiv.org/content/10.110…
Glad to see this paper finally out. It was a fascinating story when it first came out as a preprint a few years back.
Collective homeostasis of condensation-prone proteins via their mRNAs: nature.com/articles/s4158…
nature.com
Collective homeostasis of condensation-prone proteins via their mRNAs
Nature - The authors discover a homeostatic process termed interstasis, in which an increased concentration of proteins within RNA–protein condensates induces the sequestration of their own...
Collective homeostasis of condensation-prone proteins via their mRNAs: nature.com/articles/s4158…
nature.com
Collective homeostasis of condensation-prone proteins via their mRNAs
Nature - The authors discover a homeostatic process termed interstasis, in which an increased concentration of proteins within RNA–protein condensates induces the sequestration of their own...
#Postdoc opportunity at Columbia U. in New York! We are interested in candidates from biochemistry backgr. & excited about fractionation, purification and reconstitution to study autonomous clocks in the cell cycle, in colab. w/ @Aydinlab at NYU! hhmi.wd1.myworkdayjobs.com/External/job/C…
GraphVelo allows for accurate inference of multimodal velocities and molecular mechanisms for single cells | Nature Communications nature.com/articles/s4146…
LYVAC/PDZD8 is a lysosomal vacuolator | Science science.org/doi/10.1126/sc…
Perhaps our boldest hypothesis… we propose a model for RNA Structural Memory propagation @NatureCellBio, where RNA conformation is reshaped by stress, locked by RBPs, copied prion-like in condensates & passed across generations—all without altering DNA.🧵 rdcu.be/eBwPJ

A multichaperone condensate enhances protein folding in the endoplasmic reticulum: nature.com/articles/s4155…
Antiparasitic Drug Shows Power Against Alzheimer’s and Dementia today.ucsd.edu/story/antipara…
Excited to see the work by @Yale_INP students Suzhou Yang @Denethi_W w/ collabs @YaleNeuro iPSC core @jdpereira @ArabTanina and @MayoClinicNeuro @gendron_tania @NeuroUdit on #C9orf72 #ALS & #FTD finally out in @NatureNeuro! @WuTsaiYale @KavliAtYale nature.com/articles/s4159…
Nuclear speckle rejuvenation “next frontier” for treating neurodegeneration, via @EurekAlert! eurekalert.org/news-releases/…
A news article on our work. Nuclear Speckle Rejuvenation “Next Frontier” for Treating Neurodegeneration - UPMC & Pitt Health Sciences News Blog inside.upmc.com/nuclear-speckl…
Left by the tides | Pitt Med Magazine | University of Pittsburgh. A nice piece on our earlier work on identifying 12h rhythms in ‘free-living” humans. pittmed.pitt.edu/news/12-hour-b…
pittmed.pitt.edu
Left by the tides
Most of us have daily routines—and, thanks to research going back decades, we know our bodies do too. Internal clocks in our cells and genes keep certain important functions running on a 24-hour
United States Тренды
- 1. #StrangerThings5 153K posts
- 2. Thanksgiving 632K posts
- 3. Reed Sheppard 3,372 posts
- 4. Afghan 255K posts
- 5. Podz 3,116 posts
- 6. robin 71K posts
- 7. BYERS 28.3K posts
- 8. National Guard 628K posts
- 9. holly 51.5K posts
- 10. Gonzaga 8,014 posts
- 11. Dustin 84.5K posts
- 12. #AEWDynamite 21K posts
- 13. Michigan 76.6K posts
- 14. Amen Thompson 1,389 posts
- 15. Tini 8,092 posts
- 16. Erica 13.2K posts
- 17. Rahmanullah Lakanwal 96.5K posts
- 18. #Survivor49 3,032 posts
- 19. Will Richard 2,096 posts
- 20. Jardine 6,434 posts
Something went wrong.
Something went wrong.